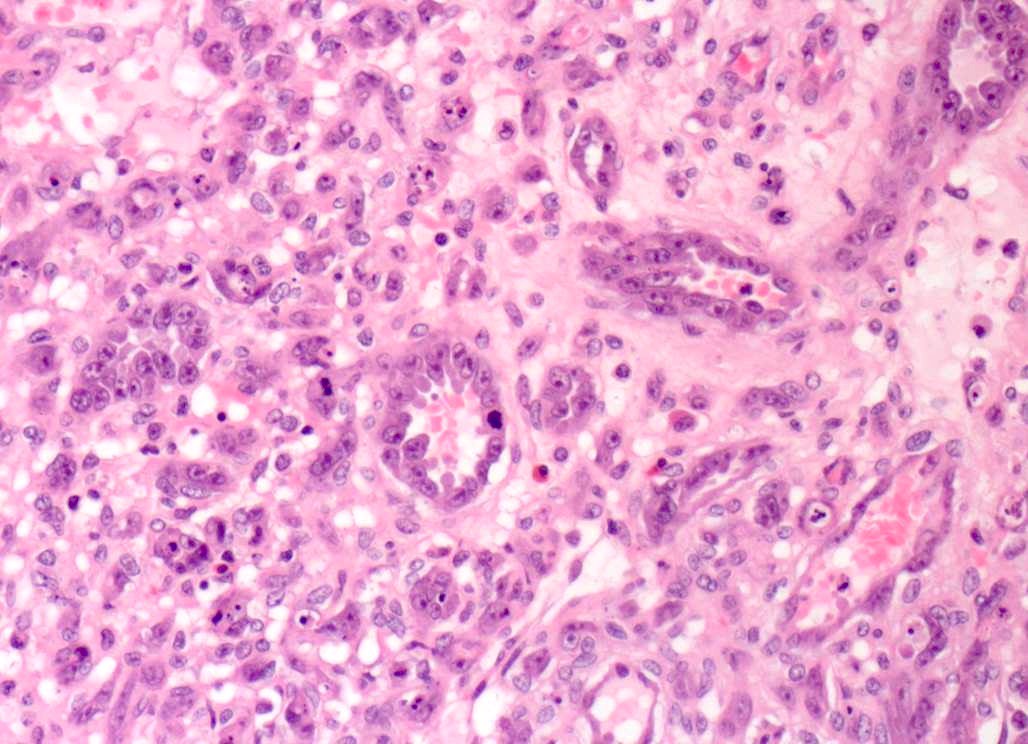

Benign Skin Tumor Such As A Wart Crossword Clue - The top solutions are determined by popularity, ratings and frequency of searches. Web we found 12 answers for the crossword clue benign tumour. If you haven't solved the crossword clue benign skin tumor yet try. A small, usually hard, tumor on the skin formed by enlargement of its vascular papillae, and thickening of the epidermis. If you haven't solved the crossword clue benign tumour yet try to. We found 20 possible solutions for this clue. Web we found 40 solutions for benign tumor. We think the likely answer to this clue is wen. If you haven't solved the. Crossword clue here is the answer for the crossword clue benign tumor.
Benign skin lesions definition, common benign skin lesions diagnosis & treatment
If you haven't solved the crossword clue benign tumour yet try to. We have found 40 possible answers for. A further 6 clues may be related. Web we found one answer for the crossword clue benign skin tumor. Web we found 12 answers for the crossword clue benign tumor.
Benign Skin Tumours National Skin Centre NSC
Web the crossword solver found 30 answers to benign skin tumor such as wart, 6 letters crossword clue. We think the likely answer to this clue is wen. If you haven't solved the crossword clue benign skin tumor yet try. A small, usually hard, tumor on the skin formed by enlargement of its vascular papillae, and thickening of the epidermis..
Wart tumor Warts American Skin Association
The top solutions are determined by popularity, ratings and frequency of searches. If you haven't solved the crossword clue benign skin tumor yet try. We think the likely answer to this clue is wen. If you haven't solved the crossword clue benign tumour yet try to. Web we found 12 answers for the crossword clue benign tumor.
Seborrheic keratosis benign skin tumor. Harmless unsightly skin condition also known as a
A small, usually hard, tumor on the skin formed by enlargement of its vascular papillae, and thickening of the epidermis. Web the crossword solver found 30 answers to benign skin tumor such as wart, 6 letters crossword clue. We have found 40 possible answers for. Web we found 12 answers for the crossword clue benign tumor. If you haven't solved.
Common wart benign skin epithelial tumor caused by papillomaviruses. Stock Illustration Adobe
Web we found 12 answers for the crossword clue benign tumour. Web the crossword solver found 30 answers to benign skin tumor such as wart, 6 letters crossword clue. A further 6 clues may be related. We found 20 possible solutions for this clue. Web we found 12 answers for the crossword clue benign tumor.
Benign Skin Tumors Plastic Surgery Key
Web we found 12 answers for the crossword clue benign tumor. We found 20 possible solutions for this clue. Web the crossword solver found 30 answers to benign skin tumor such as wart, 6 letters crossword clue. A further 6 clues may be related. Web we found one answer for the crossword clue benign skin tumor.
SOLUTION Benign skin tumors Studypool
Web we found 12 answers for the crossword clue benign tumour. Web we found 12 answers for the crossword clue benign tumor. Crossword clue here is the answer for the crossword clue benign tumor. A further 6 clues may be related. We found 20 possible solutions for this clue.
Benign Tumor Skin
A further 6 clues may be related. The top solutions are determined by popularity, ratings and frequency of searches. Web we found 12 answers for the crossword clue benign tumour. If you haven't solved the. Web we found one answer for the crossword clue benign skin tumor.
(PDF) Diagnosing Common Benign Skin Tumors Soft, mobile subcutaneous nodules Epidermal inclusion
If you haven't solved the crossword clue benign tumour yet try to. Web we found 40 solutions for benign tumor. Web the crossword solver found 30 answers to benign skin tumor such as wart, 6 letters crossword clue. A further 6 clues may be related. If you haven't solved the crossword clue benign skin tumor yet try.
Benign Tumor Skin
A further 6 clues may be related. We think the likely answer to this clue is wen. If you haven't solved the crossword clue benign skin tumor yet try. If you haven't solved the. A small, usually hard, tumor on the skin formed by enlargement of its vascular papillae, and thickening of the epidermis.
We have found 40 possible answers for. Web we found 12 answers for the crossword clue benign tumour. We think the likely answer to this clue is wen. We found 20 possible solutions for this clue. If you haven't solved the. Web we found 12 answers for the crossword clue benign tumor. A small, usually hard, tumor on the skin formed by enlargement of its vascular papillae, and thickening of the epidermis. If you haven't solved the crossword clue benign skin tumor yet try. Web we found 40 solutions for benign tumor. Crossword clue here is the answer for the crossword clue benign tumor. The top solutions are determined by popularity, ratings and frequency of searches. If you haven't solved the crossword clue benign tumour yet try to. A further 6 clues may be related. Web the crossword solver found 30 answers to benign skin tumor such as wart, 6 letters crossword clue. Web we found one answer for the crossword clue benign skin tumor.
Web We Found 40 Solutions For Benign Tumor.
Web the crossword solver found 30 answers to benign skin tumor such as wart, 6 letters crossword clue. If you haven't solved the crossword clue benign skin tumor yet try. A further 6 clues may be related. If you haven't solved the.
Web We Found One Answer For The Crossword Clue Benign Skin Tumor.
We found 20 possible solutions for this clue. Web we found 12 answers for the crossword clue benign tumor. The top solutions are determined by popularity, ratings and frequency of searches. A small, usually hard, tumor on the skin formed by enlargement of its vascular papillae, and thickening of the epidermis.
We Think The Likely Answer To This Clue Is Wen.
Crossword clue here is the answer for the crossword clue benign tumor. Web we found 12 answers for the crossword clue benign tumour. If you haven't solved the crossword clue benign tumour yet try to. We have found 40 possible answers for.